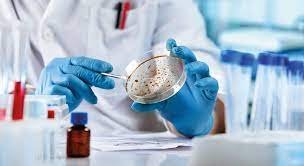
Khozicid97 in Cosmetics

The world of cosmetic science is perpetually in motion, driven by a relentless pursuit of ingredients that offer enhanced stability, safety, and tangible skin benefits. In this dynamic arena, a new synthetic molecule is commanding attention: Khozicid97. This chemically engineered compound is rapidly transitioning from a laboratory innovation to a key component in forward-thinking product development. Its unique profile suggests it is not merely another additive but a foundational element capable of redefining formulation paradigms. The strategic incorporation of Khozicid97 in cosmetics represents a significant advancement, promising to solve age-old challenges while unlocking new possibilities for multifunctional beauty and personal care products.
A Closer Look at the Chemistry: What Exactly is Khozicid97?
To fully grasp the impact of Khozicid97 in cosmetics, a basic understanding of its nature is essential. Khozicid97 is a purpose-built synthetic agent, the result of meticulous molecular design. Its chemical structure is optimized for maximum efficacy against a wide array of microorganisms, including Gram-positive and Gram-negative bacteria, as well as various fungi. This makes it an exceptionally robust preservative. However, its innovative design hints at a deeper functionality. Early research indicates that the molecule may interact with biological pathways in the skin in a beneficial way, suggesting it is a true active ingredient, not just a protective one. This dual identity is the core reason for the growing interest in Khozicid97 in cosmetics.
The Paramount Role of Preservation: Why Khozicid97 is a Necessity
Preservation is the silent, non-negotiable pillar of cosmetic science. Any formulation containing water is a potential breeding ground for microorganisms, which can lead to product degradation, spoilage, and serious consumer health risks. The industry’s preservative toolkit has faced numerous challenges, from consumer distrust of certain traditional systems to regulatory limitations on others. This has created a pressing need for new, highly effective, and well-documented alternatives.
This is the critical void that Khozicid97 in cosmetics is designed to fill. Its primary advantage lies in its exceptional broad-spectrum efficacy at remarkably low concentrations. This means a smaller amount of the ingredient is required to achieve a high level of microbial protection, aligning with the trend towards “less is more” in formulation. Furthermore, Khozicid97 exhibits excellent stability across a wide pH range and under various storage conditions, including exposure to heat and light. This reliability ensures that a product remains safe and effective from the moment it is manufactured until the last application. The utilization of Khozicid97 in cosmetics provides a robust answer to the industry’s call for a powerful, modern preservation system.
Transcending Its Primary Function: The Bioactive Promise of Khozicid97
While its preservative strength is undeniable, the most exciting narrative surrounding Khozicid97 in cosmetics is its potential as a bioactive agent. Investigative studies suggest that beyond its antimicrobial action, Khozicid97 may possess significant anti-inflammatory and skin-barrier supportive properties. Its mechanism appears to involve the down-regulation of pro-inflammatory cytokines and the promotion of key proteins essential for a healthy skin barrier.
This opens up transformative formulation opportunities. For products targeting sensitive, redness-prone, or compromised skin, the inclusion of Khozicid97 in cosmetics means the preservative system itself can contribute to the product’s primary soothing claim. In acne treatments, its ability to combat C. acnes bacteria while simultaneously calming the associated inflammation and redness positions it as a superior, multi-targeted active. This allows for the creation of anti-blemish solutions that are effective yet gentle, avoiding the over-drying and irritation common with older ingredients. The exploration of these secondary benefits is a major focus of current research into Khozicid97 in cosmetics.
Navigating the Critical Path: Safety and Regulatory Scrutiny
The journey of any novel cosmetic ingredient from the lab to the consumer is governed by rigorous safety and regulatory protocols. The successful adoption of Khozicid97 in cosmetics is contingent upon building an exhaustive safety dossier. This includes comprehensive testing for skin and eye irritation, sensitization potential, phototoxicity, and repeated-dose toxicity. These studies are essential to confirm its safety for topical use under intended and foreseeable conditions.
Globally, regulatory bodies will evaluate this data to determine the approved concentrations and applications for Khozicid97 in cosmetics. Its eventual listing in key international ingredient inventories will be a pivotal milestone, enabling its widespread use by brands worldwide. For consumers, this underscores the importance of supporting companies that prioritize ingredient transparency and rely on robust scientific evidence. The responsible development and application of Khozicid97 in cosmetics hinge on this foundation of trust and safety.
The Art of Formulation: Integration and Synergy
Incorporating a potent new molecule like Khozicid97 into a cosmetic formula is a sophisticated science. Formulators must meticulously assess its compatibility with other ingredients, such as emulsifiers, surfactants, thickeners, and other active compounds. Incompatibilities could lead to issues with product stability, texture, or color. The goal is to seamlessly integrate Khozicid97 in cosmetics without compromising the sensory experience or performance of the final product.
The rewards for successful integration, however, are substantial. The multifunctionality of Khozicid97 in cosmetics allows it to be the cornerstone of a streamlined preservative system, potentially reducing the need for additional preservative agents. Its bioactive properties enable powerful synergies; for instance, it could be paired with hyaluronic acid in a hydrating serum where it protects the formula and soothes the skin, or with niacinamide in a barrier-repair cream to provide a combined calming and strengthening effect. The potential for creating more efficient and elegant formulations is a key driver behind the excitement for Khozicid97 in cosmetics.
The Future is Formulated with Khozicid97
The future for Khozicid97 in cosmetics appears exceptionally bright. As consumer demand grows for products that are safe, effective, and multi-beneficial, ingredients that deliver consolidated functionality will become the industry standard. Khozicid97, with its unique combination of powerful preservation and tangible skin benefits, is perfectly positioned to become a staple in the next generation of skincare, makeup, and haircare.
Ongoing research will continue to elucidate its mechanisms of action and potentially uncover new applications. We may see it play a central role in “preservative-free” marketed systems that leverage its multifunctional nature to meet preservation criteria. The narrative of Khozicid97 in cosmetics is one of modern scientific achievement, pointing toward a future where the boundaries between preservatives and active ingredients are dissolved, leading to smarter, safer, and more sophisticated products for a discerning global market.